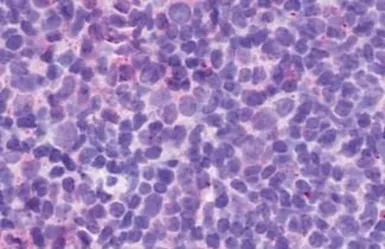
产品细节图片4

相关产品推荐更多 >
万千商家帮你免费找货
0 人在求购买到急需产品
- 详细信息
- 文献和实验
- 技术资料
- 免疫原:
Synthetic 18 amino acid peptide from 2nd cytoplasmic domain of human P2RY13 / P2Y13.
- 亚型:
IgG
- 形态:
Liquid
- 保存条件:
Store as concentrated solution. Centrifuge briefly prior to opening vial. For short-term storage (1-2 weeks), store at 4ºC. For long-term storage, aliquot and store at -20ºC or below. Avoid multiple freeze-thaw cycles.
- 克隆性:
Polyclonal
- 标记物:
Unconjugated
- 适应物种:
Human
- 保质期:
12 months from the shipping date of the product.
- 抗原来源:
Human
- 目录编号:
GTX70555
- 级别:
Primary Antibodies
- 库存:
Available
- 供应商:
GeneTex
- 宿主:
Rabbit
- 应用范围:
IHC-P
- 浓度:
1 mg/ml (Please refer to the vial label for the specific concentration.)
- 靶点:
GPR86
- 抗体英文名:
GPR86 antibody
- 抗体名:
GPR86 抗体
- 规格:
25 μg

IHC-P analysis of human stomach, adenocarcinoma tissue using GTX70555 GPR86 antibody.
Antigen retrieval : Heat-induced antigen retrieval

IHC-P analysis of human spleen tissue using GTX70555 GPR86 antibody.
Antigen retrieval : Heat-induced antigen retrieval

IHC-P analysis of brain, protoplasmic astrocyte tissue using GTX70555 GPR86 antibody.
IHC-P analysis of human lymph node, non-hodgkins lymphoma tissue using GTX70555 GPR86 antibody.
Antigen retrieval : Heat-induced antigen retrieval

IHC-P analysis of brain, substantia nigra tissue using GTX70555 GPR86 antibody.
风险提示:丁香通仅作为第三方平台,为商家信息发布提供平台空间。用户咨询产品时请注意保护个人信息及财产安全,合理判断,谨慎选购商品,商家和用户对交易行为负责。对于医疗器械类产品,请先查证核实企业经营资质和医疗器械产品注册证情况。
 文献和实验
文献和实验NSMB:徐华强 / 谢欣 / 蒋轶发现孤儿受体 GPR119 内源性配体的分子机制
糖尿病、脂肪肝和肥胖症等代谢性疾病已经成为影响人类健康的一大「杀手」,研究显示一些孤儿受体可能成为治疗这些疾病的重要靶点。 GPR119 又被称为葡萄糖依赖的促胰岛素受体(Glucose-dependent insulinotropic receptor),是 G 蛋白偶联受体(GPCR)超家族中的一种孤儿受体。由于其在糖代谢调控中的作用,GPR119 被认为是一种治疗糖尿病、脂肪肝和肥胖症等代谢性疾病的潜在药物靶点。GPR119 主要分布在胰岛 β 细胞和胃肠道 L 细胞,调节葡萄糖依赖
CD86 分子 CD86 常用单克隆抗体或代号: FUN- 1,BU63,GR65;(B7- 2) 主要表达细胞: Ba,M [B] 分子质量(kDa)和结构: gp80(IgSF) 功 能: CD28、CTLA- 4配体,提供T细胞共刺激信号 CD86 Summary: Costimulates IL-2 production and T cell proliferation
1、【仪器名称】:ZQP-86型振动切片机。 2、【仪器型号】:ZQP-86型。 3、【生产厂家】:上海之信仪器有限公司。 4、【检测适用范围】:广泛地应用于科研、教学、化工、医疗卫生等单位。其滑动灵活,在医学实验中可作为多用途的生物组织切片机,可做常规石蜡包埋切片、快速冷冻切片、火棉胶切片。
 技术资料
技术资料暂无技术资料 索取技术资料






![p38 beta antibody [4H6H6]](https://img1.dxycdn.com/2023/0711/451/6106825198874858761-14.jpg!wh200)

